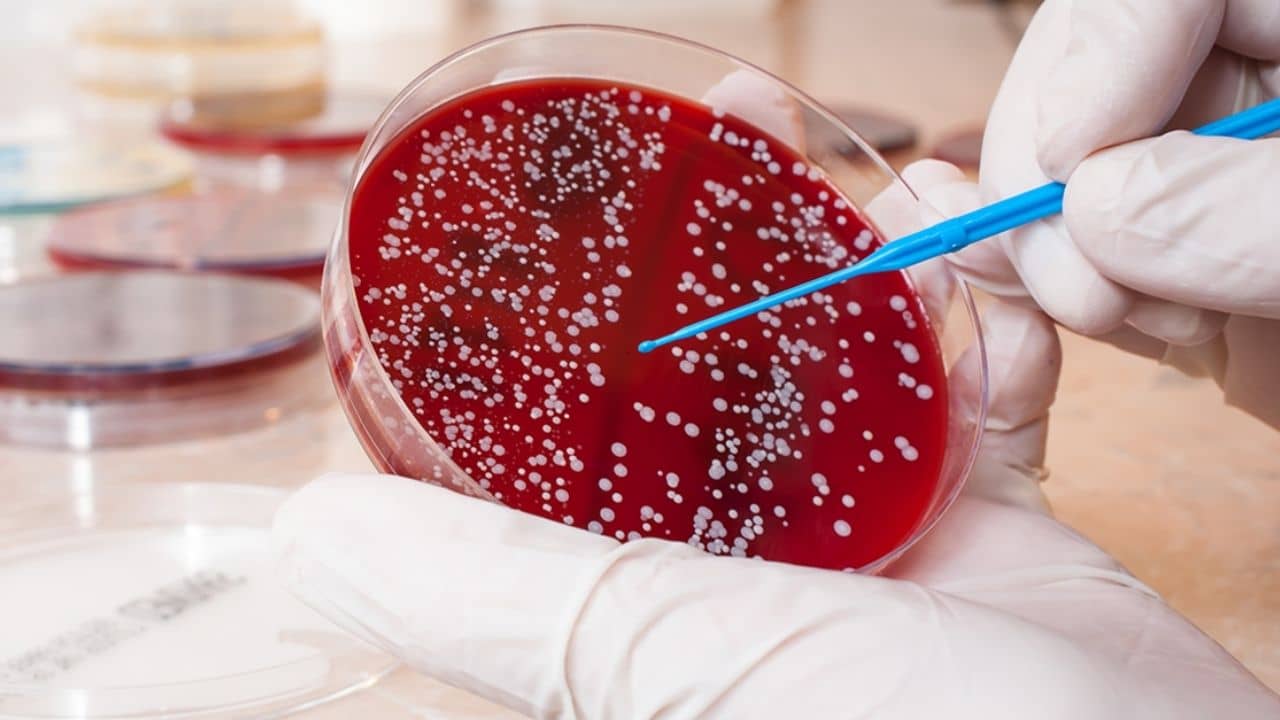
Blood Cancer Myths: ব্লাড ক্যানসার সম্বন্ধে প্রচলিত কিছু ভুল ধারণার বদলে সত্যিগুলো জেনে নিন...

যে কোনও রোগের ক্ষেত্রেই একটা সাধারণ ব্যাপার থাকেই। তা হল, রোগ যা ই হোক না কেন, সেটা নিয়ে ভুল প্রচার লেগেই থাকে। আর রোগের নাম যদি ক্যানসার হয়, তাহলে তো কথাই নেই। ব্লাড ক্যানসার সাধারণত শরীর যখন অনুন্নত রক্ত উৎপাদন শুরু করে তখনই হয়। এর ফলে শরীরের স্বাভাবিক কাজকর্ম ব্যাহত হয়। ব্লাড ক্যানসার অস্থিমজ্জাকে ব্লক করে দেয়, যা সংক্রমণ রোধ করে। এই ক্যানসারের কারণে, বিভিন্ন কোষের রক্ত বিভিন্ন রকমের কাজ করা শুরু করে।
ব্লাড ক্যানসার নিয়ে অনেক প্রচলিত কথা আছে যার অধিকাংশই মিথ্যে। ব্লাড ক্যানসারকে ঘিরে যে বিভিন্ন মিথ আছে তার মধ্যে রয়েছে কেউ কেউ যেমন বলে এটি জেনেটিক, ভিটামিন এবং সাপ্লিমেন্ট এটি রুখতে সাহায্য করতে পারে ইত্যাদি। ব্যানারঘাট্টা রোডের ফোর্টিস হাসপাতালের হেমাটো অনকোলজি, এবং বোন ম্যারো ট্রান্সপ্লান্ট বিভাগের সিনিয়র কনসালট্যান্ট ডঃ গিরিশ ভিবি এই মিথগুলির কথা বলেন এবং সেগুলি যুক্তি দিয়ে ভেঙেছেন।
মিথ: ব্লাড ক্যান্সার জেনেটিক:
ফ্যাক্ট: এটা সত্যি কোথা নয়। ধূমপান বা জেনেটিক ভেরিয়েশনকে যেমন বিআরসিএ ১ জিনকে ব্লাড ক্যান্সারের ঝুঁকির কারণ হিসেবে দায়ী করা যায় না। একটি স্বাস্থ্যকর জীবনযাত্রার সঙ্গে ক্যানসারের জেনেটিক ঝুঁকিও হ্রাস পায়।
মিথ: ভিটামিন এবং সাপ্লিমেন্ট খেলে ব্লাড ক্যানসারের ঝুঁকি কমে:
ফ্যাক্ট: এরকম বিবৃতিকে সমর্থন করার মতো কোনও বৈজ্ঞানিক তথ্য নেই। এছাড়াও, ক্যানসারের ক্ষেত্রে কৃত্রিমভাবে তৈরি করা ভিটামিন ক্যাপসুল বা সাপ্লিমেন্ট খাওয়ার পরিবর্তে সুষম খাবার খাওয়ার পরামর্শ দেওয়া হয়।
মিথ: ব্লাড ক্যানসারে আক্রান্ত ব্যক্তিদের বোন ম্যারো (অস্থি মজ্জা) ট্রান্সপ্ল্যান্ট করতে হয়:
ফ্যাক্ট: অস্থি মজ্জা ব্যক্তির শরীরের ভেতরের অবস্থা, চিকিৎসা, প্রতিক্রিয়া এবং অন্যান্য অনেকগুলো কারণের উপর নির্ভর করে। যেকোনো ব্লাড ক্যানসারের রোগীদেরই যে বোন ম্যারো ট্রান্সপ্ল্যান্ট করাতে হবে এমনটা নয়। প্রযুক্তির উন্নতির সঙ্গে সঙ্গে রোগীদের চিকিৎসার পদ্ধতিরও উন্নতি হয়েছে।
মিথ: রক্তশূন্যতা ব্লাড ক্যানসারের উৎস:
উত্তর: ব্লাড ক্যানসারের সঙ্গে লড়াই করা রোগীদের মধ্যে রক্তাল্পতা হতে পারে। কিন্তু এটা কখনই এই ক্যানসারের উৎস হতে পারে না। রক্তাল্পতার বিকাশের প্রধান কারণ হল লোহিত রক্তকণিকা বা হিমোগ্লোবিনের অভাব। কারণ এটি অক্সিজেনের উপর নির্ভর করে। রক্তস্বল্পতার বিকাশের জন্য বিভিন্ন স্বাস্থ্যগত কারণ রয়েছে। তাদের মধ্যে অন্যতম হল আয়রনের ঘাটতি।
মিথ: ব্লাড ক্যানসার নিরাময় করা যায় না:
উত্তর: প্রযুক্তির অগ্রগতির সঙ্গে সঙ্গে ক্যানসারের চিকিৎসার উন্নতি হচ্ছে। মানুষ আগের চেয়ে বেশি দিন এই রোগের সঙ্গে লড়াই করতে পারছে। অনেকেই এই লড়াইয়ে রীতিমতো সফলও হচ্ছে। থেরাপিউটিক এজেন্ট যেমন কেমোথেরাপি, রেডিওথেরাপি, টার্গেটেড থেরাপি, বোন ম্যারো ট্রান্সপ্ল্যান্ট এবং ইমিউনোথেরাপি গুলো ক্যানসারকে হারাতে দারুণভাবে সাহায্য করছে। প্রাথমিক পর্যায়ে এই রোগ নির্ণয়ের সঙ্গে সঙ্গে বেঁচে থাকার সম্ভাবনাও বৃদ্ধি পায়।
আরও পড়ুন:
আরও পড়ুন: